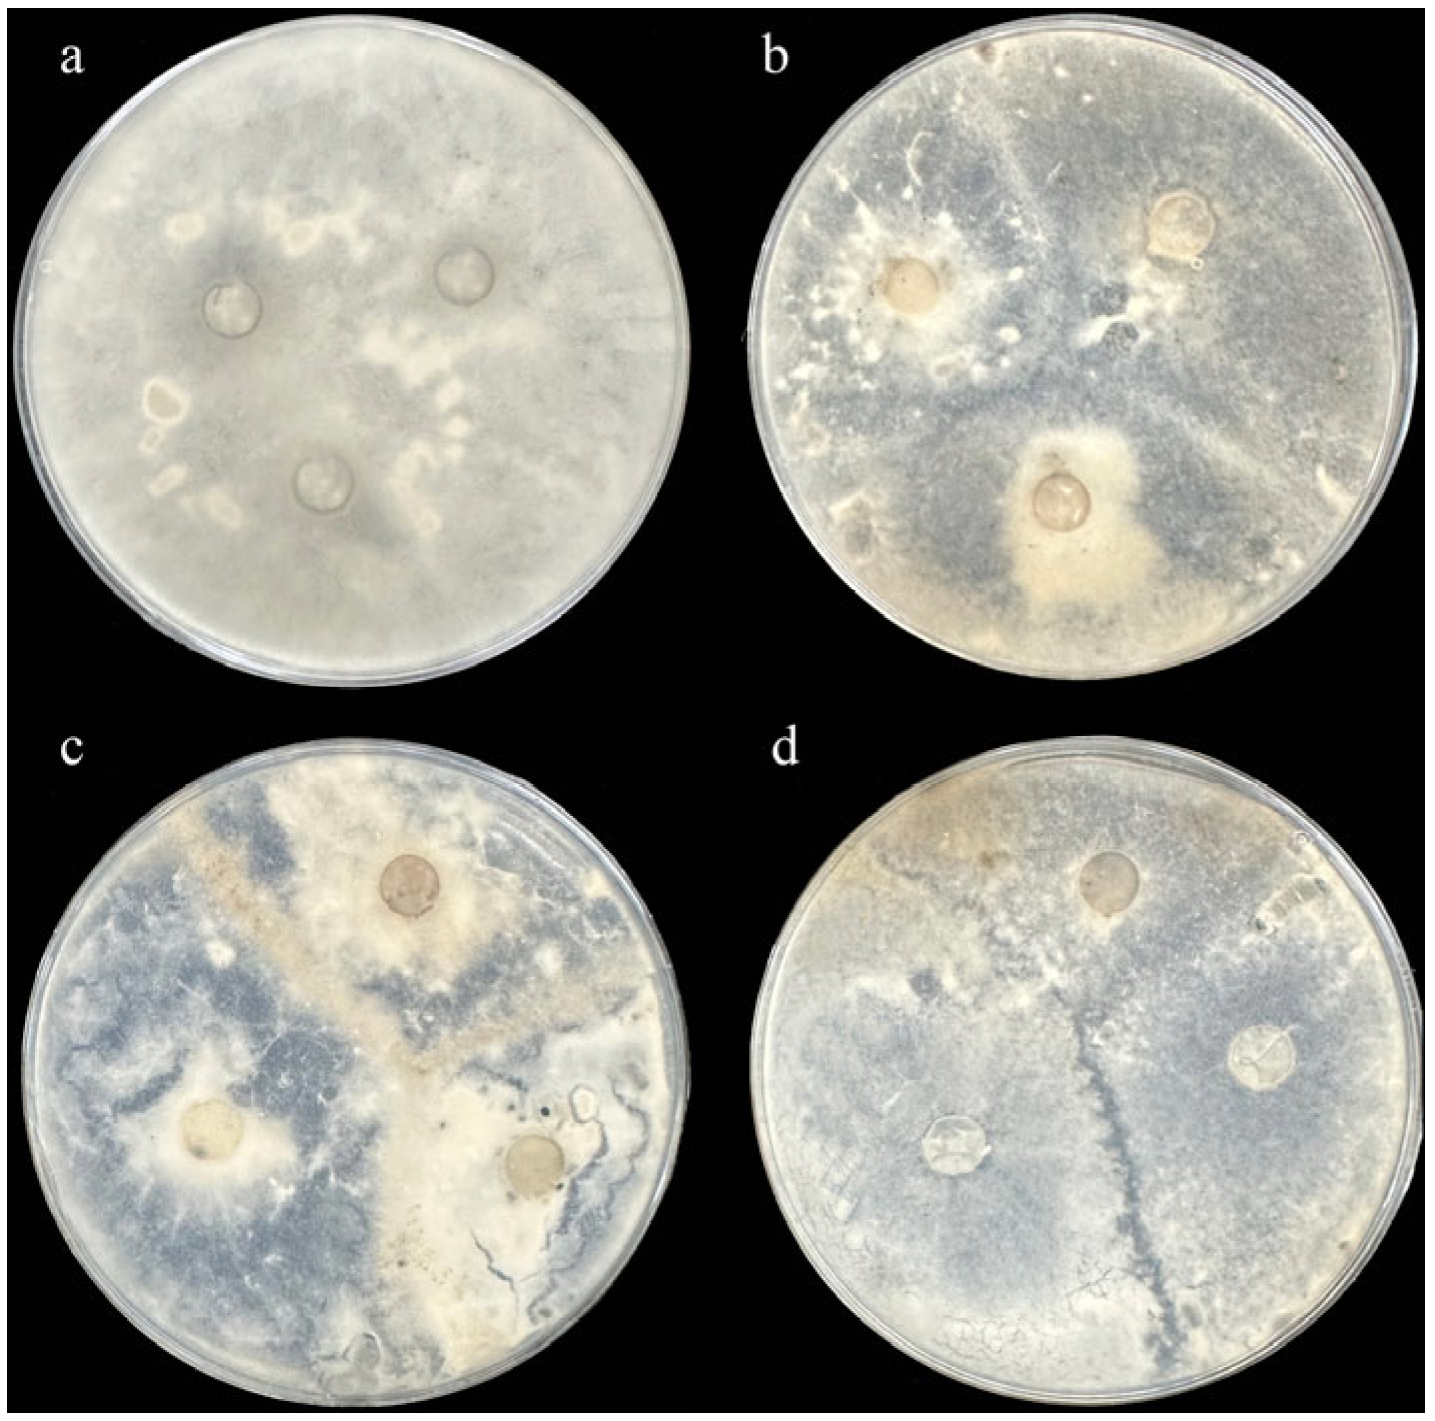

Putative Transcriptional Regulation of HaWRKY33-AOA251SVV7 Complex-Mediated Sunflower Head Rot by Transcriptomics and Proteomics
Abstract
1. Introduction
2. Results
2.1. Identification of Sunflower Resistance Resources Against S. sclerotiorum
2.1.1. Field Identification of Sunflower Head Rot Disease
2.1.2. Identification of the Affinity of S. sclerotiorum Mycelium Toward Sunflowers
2.1.3. SSR Analysis Reveals the Genetic Diversity of S. sclerotiorum Populations in Sunflower
2.1.4. Indoor Identification of Sunflower Head Rot Disease
2.2. Transcriptome Analysis of Sunflower Disease-Resistant and Susceptible Varieties in Response to S. sclerotiorum Infection
2.2.1. GO and KEGG Enrichment Analysis of Differentially Expressed Genes
2.2.2. RT-qPCR Validation of Differentially Expressed Genes
2.3. Bioinformatics Analysis of the HaWRKY33 Gene in Sunflowers
2.3.1. Yeast Two-Hybrid Screening by HaWRKY33
2.3.2. Prediction of Candidate Interacting Proteins with HaWRKY33 by AlphaFold 3
2.3.3. Prediction of Key Amino Acid Sites for HaWRKY33-AOA251SVV7 by PyMOL
3. Discussion
4. Materials and Methods
4.1. Identification of Sunflower Resources Resistant to S. sclerotiorum
4.1.1. Sunflower Head Rot Field Identification Criteria
4.1.2. Indoor Identification for Sunflower Head Rot Disease
4.2. Research on the Genetic Diversity of S. sclerotiorum and Methods for Predicting Dominant Strains
4.2.1. Isolation and Purification of S. sclerotiorum
4.2.2. Identification of the Affinity of S. sclerotiorum Mycelium
4.2.3. Assessment of SSR Genetic Diversity in S. sclerotiorum Strains from Sunflower
4.2.4. Statistical Analysis of Genetic Diversity and Inference of Dominant Varieties
4.3. Transcriptome Sequencing Analysis
4.3.1. Sample Collection
4.3.2. RNA Extraction and Library Construction
4.3.3. RNA Sequencing and Differential Gene Expression Analysis
4.3.4. Differentially Expressed Gene Analysis
4.3.5. Quantitative Real-Time PCR Validation
4.4. Bioinformatics Analysis of Genes Using AlphaFold 3 and PyMOL Software
4.4.1. AlphaFold 3 Prediction of Protein Interaction Site Analysis
4.4.2. Molecular Docking and Bioinformatic Mutation Simulation Analysis Using PyMOL
5. Conclusions
Supplementary Materials
Author Contributions
Funding
Data Availability Statement
Conflicts of Interest
References
- Pilorgé, E. Sunflower in the global vegetable oil system: Situation, specificities and perspectives. Oilseeds Fats Crops Lipids 2020, 27, 34. [Google Scholar] [CrossRef]
- Shehzad, M.A.; Nawaz, F.; Ahmad, F.; Ahmad, N.; Masood, S. Protective effect of potassium and chitosan supply on growth, physiological processes and antioxidative machinery in sunflower (Helianthus annuus L.) under drought stress. Ecotoxicol. Environ. Saf. 2020, 187, 109841. [Google Scholar] [CrossRef] [PubMed]
- Hamid, S.; Ahmad, I.; Akhtar, M.J.; Iqbal, M.N.; Shakir, M.; Tahir, M.; Rasool, A.; Sattar, A.; Khalid, M.; Ditta, A.; et al. Bacillus subtilis Y16 and biogas slurry enhanced potassium to sodium ratio and physiology of sunflower (Helianthus annuus L.) to mitigate salt stress. Environ. Sci. Pollut. Res. 2021, 28, 38637–38647. [Google Scholar] [CrossRef] [PubMed]
- Ren, L.; Wang, H. China’s Sunflower Capital—Gannan. China Cty. Econ. Newsp. 2007, 5, 14. [Google Scholar]
- Boland, G.J.; Hall, R. Index of plant hosts of Sclerotinia sclerotiorum. Can. J. Plant Pathol. 1994, 16, 93–108. [Google Scholar] [CrossRef]
- Kohn, L.M. The clonal dynamic in wild and agricultural plant–pathogen populations. Can. J. Bot. 1995, 73, 1231–1240. [Google Scholar] [CrossRef]
- Wang, Z.; Ma, L.Y.; Cao, J.; Li, Y.L.; Ding, L.N.; Zhu, K.M.; Yang, Y.H.; Tan, X.L. Recent advances in mechanisms of plant defense to Sclerotinia sclerotiorum. Front. Plant Sci. 2019, 10, 1314. [Google Scholar] [CrossRef]
- Meng, Q. Study on the Occurrence Regularity and Control Techniques of Sclerotinia sclerotiorum in Sunflower. Master’s Thesis, Chinese Academy of Agricultural Sciences, Beijing, China, 2013. [Google Scholar]
- Shi, X. Race Identification, Genetic Diversity and Evaluation of Resistance Level of Different Sunflower Varieties Against Orobanche cumana Wallr. Ph.D. Thesis, Inner Mongolia Agricultural University, Hohhot, China, 2017. [Google Scholar]
- Shang, Y.; Xiao, G.; Zheng, P.; Cen, K.; Zhan, S.; Wang, C. Divergent and convergent evolution of fungal pathogenicity. Genome Biol. Evol. 2016, 8, 1374–1387. [Google Scholar] [CrossRef]
- Schwartz, H.F.; Steadman, J.R. Factors affecting sclerotium populations of, and apothecium production by, Sclerotinia sclerotiorum. Phytopathology 1978, 68, 383–388. [Google Scholar] [CrossRef]
- Kohn, L.M.; Stasovski, E.; Carbone, I.; Royer, J.; Anderson, J.B. Mycelial incompatibility and molecular markers identify genetic variability in field populations of Sclerotinia sclerotiorum. Phytopathology 1991, 81, 480–485. [Google Scholar] [CrossRef]
- Silva, R.A.; Ferro, C.G.; Lehner, M.D.S.; Paula, T.J., Jr.; Mizubuti, E.S. The population of Sclerotinia sclerotiorum in Brazil is structured by mycelial compatibility groups. Plant Dis. 2021, 105, 3376–3384. [Google Scholar] [CrossRef]
- Liu, J.; Meng, Q.; Zhang, Y.; Xiang, H.; Li, Y.; Shi, F.; Ma, L.; Liu, C.; Liu, Y.; Su, B.; et al. Mycelial compatibility group and genetic variation of sunflower Sclerotinia sclerotiorum in Northeast China. Physiol. Mol. Plant Pathol. 2018, 102, 185–192. [Google Scholar] [CrossRef]
- Li, W. Study on the nutrient affinity group of Fusarium oxysporum pathogenic bacteria. J. Zhejiang Agric. 2001, 2, 18–23. [Google Scholar]
- Brewster, R.C.; Weinert, F.M.; Garcia, H.G.; Song, D.; Rydenfelt, M.; Phillips, R. The transcription factor titration effect dictates level of gene expression. Cell 2014, 156, 1312–1323. [Google Scholar] [CrossRef] [PubMed]
- Pabo, C.O.; Sauer, R.T. Transcription factors: Structural families and principles of DNA recognition. Annu. Rev. Biochem. 1992, 61, 1053–1095. [Google Scholar] [CrossRef] [PubMed]
- Weidemüller, P.; Kholmatov, M.; Petsalaki, E.; Zaugg, J.B. Transcription factors: Bridge between cell signaling and gene regulation. Proteomics 2021, 21, 2000034. [Google Scholar] [CrossRef]
- Zhang, Y.; Zhao, J.; Li, Y.; Yuan, Z.; He, H.; Yang, H.; Qu, H.; Ma, C.; Qu, S. Transcriptome analysis highlights defense and signaling pathways mediated by rice pi21 gene with partial resistance to Magnaporthe oryzae. Front. Plant Sci. 2016, 7, 1834. [Google Scholar] [CrossRef]
- Choi, N.; Im, J.H.; Lee, E.; Lee, J.; Choi, C.; Park, S.R.; Hwang, D.J. WRKY10 transcriptional regulatory cascades in rice are involved in basal defense and Xa1-mediated resistance. J. Exp. Bot. 2020, 71, 3735–3748. [Google Scholar] [CrossRef]
- Li, Y. Cloning and Expression Analysis of Sunflower HaWRKY33. Master’s Thesis, Inner Mongolia Agricultural University, Hohhot, China, 2021. [Google Scholar]
- Lin, M.; Gong, M.; Jia, L. Field inoculation methods for sunflower sclerotinia rot and research on variety resistance. Chin. J. Oil Crop Sci. 2014, 36, 113–116. [Google Scholar]
- Li, Y.G.; Zhang, X.; Zhang, R.; Liu, J.X.; Ali, E.; Ji, P.; Pan, H.Y. Occurrence of seedling blight caused by Fusarium tricinctum on rice in China. Plant Dis. 2019, 103, 1789. [Google Scholar] [CrossRef]
- Min, L.; Jin, G.; Bing, X.; Ming, C.; Yan, L. Experiment on inoculation methods for sunflower sclerotinia rot. J. Jilin Agric. Univ. 2004, 4, 381–382. [Google Scholar]
- Gao, H.; Zhu, L.; Liu, T.; Leng, X.; Zhu, Z.; Xie, W.; Lv, H.; Jin, Z.; Wu, P.; Zhang, Z. Identification of a Novel OsCYP2 Allele that Was Involved in Rice Response to Low Temperature Stress. Phyton 2023, 92, 1743. [Google Scholar] [CrossRef]
- Moore, S.S.; Sargeant, L.L.; King, T.J.; Mattick, J.S.; Georges, M.; Hetzel, D.J.S. The conservation of dinucleotide microsatellites among mammalian genomes allows the use of heterologous PCR primer pairs in closely related species. Genomics 1991, 10, 654–660. [Google Scholar] [CrossRef] [PubMed]
- Yuan, L.; Warburton, M.; Hai, L.; Huang, Z.; Khairallah, M.; Zhi, L.; Bin, P.; Cheng, L. A comparative study on the genetic diversity of maize inbred lines using RFLP, SSR, AFLP, and RAPD markers. Acta Genet. Sin. 2000, 8, 725–733+756. [Google Scholar]
- Rui, H.; Yin, P.; Long, W. Application of SSR markers in sugarcane genetic breeding. Sugarcane Ind. 2006, 6, 1–4. [Google Scholar]
- Chu, L.; Hua, Z. Genetic differences between different hyphal affinity groups of soybean sclerotium fungus. Soybean Sci. 2014, 33, 718–723. [Google Scholar]
- Sirjusingh, C.; Kohn, L.M. Characterization of microsatellites in the fungal plant pathogen, Sclerotinia sclerotiorum. Mol. Ecol. Notes 2001, 1, 267–269. [Google Scholar] [CrossRef]
- Liu, M.; Ou, Q.; Gong, J.; Wan, J. Studies on the method of inoculating Sclerotinia sclerotiorum. J. Jilin Agric. Univ. 2004, 4, 381–382. [Google Scholar]
- Yan, Z.; Qing, Z.; Tan, Z. Identification of NBS-LRR family genes associated with sugarcane resistance to tip rot disease based on high-precision transcriptomics sequencing technology. Genom. Appl. Biol. 2022, 41, 1952–1963. [Google Scholar]
- Lin, F.; Ling, D.; Qin, L.; Qin, Z. Transcriptome analysis of Chinese cabbage leaves in response to sclerotinia infection. J. Trop. Crop Sci. 2023, 44, 1106–1113. [Google Scholar]
- Chen, X.; Hao, X.; Akhberdi, O.; Zhu, X. Genomic and transcriptomic survey provides insights into molecular basis of pathogenicity of the sunflower pathogen Phoma macdonaldii. J. Fungi 2023, 9, 520. [Google Scholar] [CrossRef] [PubMed]
- Wang, Y.J. Genetic Diversity and Pathogenicity Variation of Sclerotinia sclerotiorum in Sunflower. Master’s Thesis, Inner Mongolia Agricultural University, Hohhot, China, 2011. [Google Scholar]
- Jia, R.F.; Li, M.; Zhang, J.; Yun, X.P.; Meng, Q.L.; Zhao, J. Mycelium compatibility group of sunflower Sclerotinia minor and its biological characteristics, pathogenicity and mating type in Inner Mongolia Autonomous Region. J. Plant Prot. 2019, 46, 1222–1232. [Google Scholar]
- Zhao, M.; Yi, B.; Liu, X.; Wang, D.; Song, D.; Sun, E.; Cui, L.; Liu, J.; Feng, L. Comparative transcriptome analysis in two contrasting genotypes for Sclerotinia sclerotiorum resistance in sunflower. PLoS ONE 2024, 19, e0315458. [Google Scholar] [CrossRef] [PubMed]
- Ishihama, N.; Yamada, R.; Yoshioka, M. Phosphorylation of the Nicotiana benthamiana WRKY8 transcription factor by MAPK functions in the defense response. Plant Cell 2011, 23, 1153–1170. [Google Scholar] [CrossRef]
- Mao, G.; Meng, X.; Liu, Y. Phosphorylation of a WRKY transcription factor by two pathogen-responsive MAPKs drives phytoalexin biosynthesis in Arabidopsis. Plant Cell 2011, 23, 1639–1653. [Google Scholar] [CrossRef]
- Godbole, R.C.; Pable, A.A.; Singh, S. Interplay of transcription factors orchestrating the biosynthesis of plant alkaloids. 3 Biotech 2022, 12, 250. [Google Scholar] [CrossRef]
- Kull, L.S.; Pedersen, W.L.; Palmquist, D.; Hartman, G.L. Mycelial compatibility grouping and aggressiveness of Sclerotinia sclerotiorum. Plant Disease 2004, 88, 325–332. [Google Scholar] [CrossRef]
- Li, W.; Pang, S.; Lu, Z. Function and mechanism of WRKY transcription factors in abiotic stress responses of plants. Plants 2020, 9, 1515. [Google Scholar] [CrossRef]
- Wani, S.H.; Anand, S.; Singh, B. WRKY transcription factors and plant defense responses: Latest discoveries and future prospects. Plant Cell Rep. 2021, 40, 1071–1085. [Google Scholar] [CrossRef]
- Wang, H.; Chen, W.; Xu, Z. Functions of WRKYs in plant growth and development. Trends Plant Sci. 2023, 28, 630–645. [Google Scholar] [CrossRef]
- Yan, Z. Cloning and Functional Analysis of MdWRKY33 Gene in Apple. Master’s thesis, Shenyang Agricultural University, Shenyang, China, 2018. [Google Scholar]
- Duo, H.; Yin, M.; Wang, R. Molecular mechanisms of resistance and future perspectives in plant breeding strategies against Sclerotinia sclerotiorum. New Crops 2025, 2, 100046. [Google Scholar] [CrossRef]
- Chen, Y.; Zhang, J. Multiple functions and regulatory networks of WRKY33 and its orthologs. Gene 2024, 931, 148899. [Google Scholar] [CrossRef] [PubMed]
- Wang, X.; Gao, M.; Kong, Y.; Yu, Q.; Yao, L.; Li, X.; Li, W.; Liu, W.; Hou, R.; Zhang, L.; et al. Overexpression of a Malus baccata (L.) borkh WRKY factor gene MbWRKY33 increased high salinity stress tolerance in Arabidopsis thaliana. Int. J. Mol. Sci. 2025, 26, 5833. [Google Scholar] [CrossRef]
- Talmo, N.; Ranjan, A. Comparative insights into soybean and other oilseed crops’ defense mechanisms against Sclerotinia sclerotiorum. Front. Plant Sci. 2025, 16, 1616824. [Google Scholar] [CrossRef]
- Tuncel, A.; Pan, C.; Clem, J.S.; Liu, D.; Qi, Y. CRISPR–Cas applications in agriculture and plant research. Nat. Rev. Mol. Cell Biol. 2025, 26, 419–441. [Google Scholar] [CrossRef]
- Roshna, K.; Vinoth, S.; Arun, M.; Ramya, B.; Sivaranjini, A.; Anand, A.V.; Gurusaravanan, P. Advances and perspectives in genetic engineering and the CRISPR/Cas-based technology for oil crop enhancement. In CRISPR and Plant Functional Genomics; CRC Press: Boca Raton, FL, USA, 2024; pp. 332–347. [Google Scholar]

| MCGs | Number of Isolates | Isolate Designations |
|---|---|---|
| 1 | 21 | 1, 16, 18, 26, 27, 28, 29, 30, 31, 33, 35, 36, 37, 38, 40, 41, 39, 34, 49, 50, 62 |
| 2 | 8 | 42, 43, 44, 45, 46, 47, 48, 51 |
| 3 | 11 | 2, 3, 4, 5, 6, 7, 11, 13, 15, 19, 24 |
| 4 | 9 | 8, 9, 10, 12, 14, 17, 20, 21, 32 |
| 5 | 11 | 22, 23, 25, 52, 53, 54, 55, 60, 61, 63 |
| 6 | 7 | 56, 57, 58, 59, 64, 65, 66 |
| Gene Name | Protein Name | Genebank | iPTM | PTM |
|---|---|---|---|---|
| DEAD-box ATP-dependent RNA helicase 17 | A0A251V503 | XP_022027146.1 | 0.19 | 0.4 |
| pectin acetylesterase 8-like | A0A251SVV7 | XP_022001922.1 | 0.43 | 0.52 |
| uncharacterized protein LOC110937345 isoform X2 | A0A251V192 | XP_022035446.1 | 0.39 | 0.34 |
| glucan endo-1,3-beta-glucosidase-like | A0A251TFA3 | XP_021994768.1 | 0.26 | 0.46 |
| putative elongation factor 1-alpha | EF1A | OTG20831.1 | 0.15 | 0.39 |
| putative ribosomal protein L10P | AOA251TCN0 | OTG08828.1 | 0.16 | 0.29 |
| HaWRKY33 | AOA251SVV7 |
|---|---|
| ASN-473 | ARG-86 |
| SER-474 | ARG-389 |
| TYR-472 | ASP-392 |
| TYR-206 | |
| LYS-190 | |
| LYS-190 | PHE-391 |
| GLN-193 | LYS-298 |
| ASP-212 | GLU-23 |
| ARG-189 | GLU-344 |
| HIS-387 |
| Amino Acid | Mutated Amino Acid | Reason |
|---|---|---|
| GLN-193 | GLN-193-TRP | TRP is a hydrophobic amino acid that may disrupt existing hydrogen bond networks or hydrophilic interactions. |
| GLN-193-LYS | LYS is positively charged (-NH3+) and may disrupt the original electrostatic equilibrium. | |
| GLN-193-PRO | The ring structure of PRO limits the φ angle, which may disrupt the α-helix or β-fold. | |
| ARG-189 | ARG-189-GLU | May damage salt bridges or cause electrostatic repulsion. |
| ARG-189-PHE | Introducing hydrophobic mutations in key regions of positively charged residues disrupts protein–ligand binding or protein–protein interactions. | |
| ARG-189-PRO | The ring structure of PRO may disrupt α-helices or β-folds. |
| Resistance Evaluation | Disease Index |
| I | 0 |
| R | <10 |
| MR | 10.1~30 |
| MS | 30.1~50 |
| S | 50.1~75 |
| HS | >75.1 |
Disclaimer/Publisher’s Note: The statements, opinions and data contained in all publications are solely those of the individual author(s) and contributor(s) and not of MDPI and/or the editor(s). MDPI and/or the editor(s) disclaim responsibility for any injury to people or property resulting from any ideas, methods, instructions or products referred to in the content. |
© 2025 by the authors. Licensee MDPI, Basel, Switzerland. This article is an open access article distributed under the terms and conditions of the Creative Commons Attribution (CC BY) license (https://creativecommons.org/licenses/by/4.0/).
Share and Cite
Zhang, Q.; Wang, X.; Fu, G.; Zhang, M.; Leng, X.; Kong, Z.; Wang, J.; Zhang, Y.; Hu, X.; Yu, H.; et al. Putative Transcriptional Regulation of HaWRKY33-AOA251SVV7 Complex-Mediated Sunflower Head Rot by Transcriptomics and Proteomics. Plants 2025, 14, 3018. https://doi.org/10.3390/plants14193018
Zhang Q, Wang X, Fu G, Zhang M, Leng X, Kong Z, Wang J, Zhang Y, Hu X, Yu H, et al. Putative Transcriptional Regulation of HaWRKY33-AOA251SVV7 Complex-Mediated Sunflower Head Rot by Transcriptomics and Proteomics. Plants. 2025; 14(19):3018. https://doi.org/10.3390/plants14193018
Chicago/Turabian StyleZhang, Qian, Xin Wang, Guoyu Fu, Meishan Zhang, Xueyu Leng, Zicheng Kong, Jing Wang, Yanjie Zhang, Xiaoxin Hu, Huan Yu, and et al. 2025. "Putative Transcriptional Regulation of HaWRKY33-AOA251SVV7 Complex-Mediated Sunflower Head Rot by Transcriptomics and Proteomics" Plants 14, no. 19: 3018. https://doi.org/10.3390/plants14193018
APA StyleZhang, Q., Wang, X., Fu, G., Zhang, M., Leng, X., Kong, Z., Wang, J., Zhang, Y., Hu, X., Yu, H., & Zhang, Z. (2025). Putative Transcriptional Regulation of HaWRKY33-AOA251SVV7 Complex-Mediated Sunflower Head Rot by Transcriptomics and Proteomics. Plants, 14(19), 3018. https://doi.org/10.3390/plants14193018






